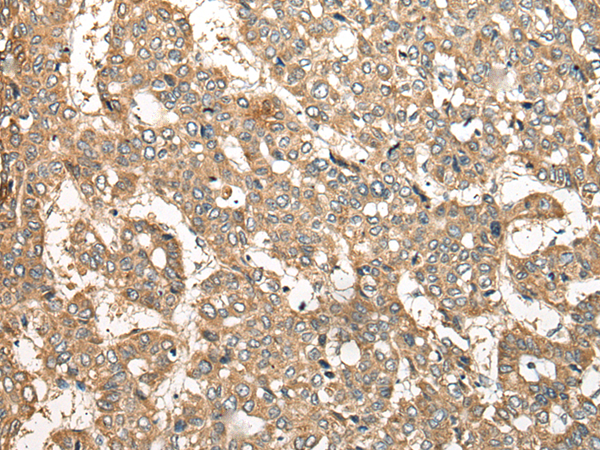

-
分类: 科研抗体货号: P09430别名: CAMKKA应用: WB,IHC反应种属: Human, Mouse, Rat
-
分类: 科研抗体货号: P09409别名: Kur; FBB18; CILD26; C21orf48; C21orf59应用: WB,IHC反应种属: Human, Mouse, Rat
-
分类: 科研抗体货号: P09429别名: CLSP应用: IHC反应种属: Human
-
分类: 科研抗体货号: P09408别名: KNP-I应用: WB,IHC反应种属: Human
-
分类: 科研抗体货号: P09428别名: FAM26C应用: IHC反应种属: Human, Mouse
-
分类: 科研抗体货号: P09407别名: RDMS; SMDAX; LRRC76; YF5/A2; C21orf2应用: IHC反应种属: Human
-
分类: 科研抗体货号: P09427别名: NDP52应用: WB反应种属: Human
-
分类: 科研抗体货号: P09405别名: sen15; C1orf19应用: WB,IHC反应种属: Human, Mouse
-
分类: 科研抗体货号: P09424别名: CNB; CNB1; CALNB1应用: IHC反应种属: Human, Mouse, Rat
-
分类: 科研抗体货号: P09404别名: RESA1; SELRC1; C1orf163应用: WB,IHC反应种属: Human, Mouse

鄂公网安备42018502007531号
鄂公网安备42018502007531号

